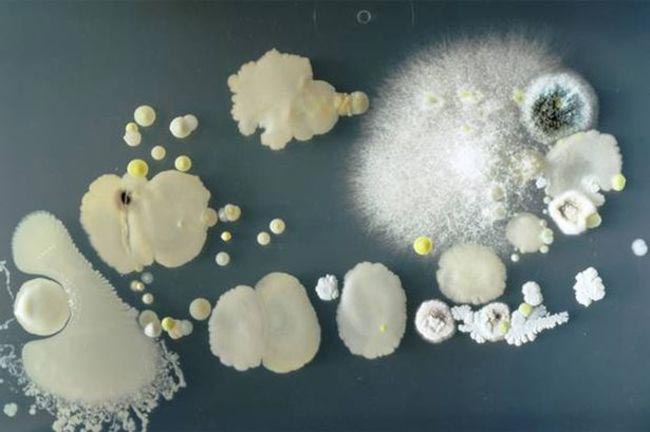
не лизать свой телефон, бактерии на телефоне, мобильный телефон а чашке Петри, какие бактерии на телефоне

Веская причина никогда не лизать свой телефон
Если вы не знаете, то всё к чему регулярно прикасаются ваши руки (а тем более руки других людей) - крайне грязные вещи. Самыми яркими представителями этих "популярных" вещей являются: деньги, дверные ручки, поручни и конечно же мобильные телефоны. Если у вас когда-нибудь возникало безумное желание лизнуть свой телефон или по какой-то причине взять его в рот, то вот вам достойная причина не делать этого, и на этот раз мы говорим не о голословных нравоучениях.
Ученые студенты из английского Университета Суррея решили провести эксперимент и проверить свои телефоны на бактериологическую опасность. Для этого они поместили свои смартфоны в чашки Петри, в агар-желеобразную субстанцию, получаемую из водорослей. Спустя 3 дня они сделали крупным планом сфотографировали то, что "выросло"
![Веская причина никогда не лизать свой телефон не лизать свой телефон, бактерии на телефоне, мобильный телефон а чашке Петри, какие бактерии на телефоне]()
Трехдневные результаты эксперимента оказались довольно мрачными. К счастью, большинство обнаруженных бактерий не представляли никакой опасности для человека. Исключением являлся только золотистый стафилококк, который может являться причиной как легких кожных инфекции, так и смертельно опасных заболеваний, таких как пневмония, менингит, остеомиелит
![Веская причина никогда не лизать свой телефон не лизать свой телефон, бактерии на телефоне, мобильный телефон а чашке Петри, какие бактерии на телефоне]()
Эксперимент доказал, что телефон хранит не только переписку и контакты, но также и историю ваших личных физических контактов. Старший преподаватель в области молекулярной биологии Саймон Парк, рекомендует чистить мобильный телефон мягким дезинфицирующим средством хотя бы раз в неделю, чтобы предотвратить развитие и накопление бактерий
![Веская причина никогда не лизать свой телефон не лизать свой телефон, бактерии на телефоне, мобильный телефон а чашке Петри, какие бактерии на телефоне]()